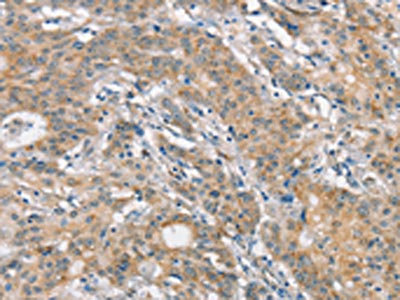

FZD1 Antibody
-
中文名稱:FZD1兔多克隆抗體
-
貨號:CSB-PA991727
-
規格:¥1100
-
圖片:
-
The image on the left is immunohistochemistry of paraffin-embedded Human thyroid cancer tissue using CSB-PA991727(FZD1 Antibody) at dilution 1/15, on the right is treated with synthetic peptide. (Original magnification: ×200)
-
The image on the left is immunohistochemistry of paraffin-embedded Human gastric cancer tissue using CSB-PA991727(FZD1 Antibody) at dilution 1/15, on the right is treated with synthetic peptide. (Original magnification: ×200)
-
-
其他:
產品詳情
-
Uniprot No.:
-
基因名:
-
別名:FZD1; Frizzled-1; Fz-1; hFz1; FzE1
-
宿主:Rabbit
-
反應種屬:Human,Mouse,Rat
-
免疫原:Synthetic peptide of Human FZD1
-
免疫原種屬:Homo sapiens (Human)
-
標記方式:Non-conjugated
-
抗體亞型:IgG
-
純化方式:Antigen affinity purification
-
濃度:It differs from different batches. Please contact us to confirm it.
-
保存緩沖液:-20°C, pH7.4 PBS, 0.05% NaN3, 40% Glycerol
-
產品提供形式:Liquid
-
應用范圍:ELISA,IHC
-
推薦稀釋比:
Application Recommended Dilution ELISA 1:1000-1:2000 IHC 1:25-1:100 -
Protocols:
-
儲存條件:Upon receipt, store at -20°C or -80°C. Avoid repeated freeze.
-
貨期:Basically, we can dispatch the products out in 1-3 working days after receiving your orders. Delivery time maybe differs from different purchasing way or location, please kindly consult your local distributors for specific delivery time.
-
用途:For Research Use Only. Not for use in diagnostic or therapeutic procedures.
相關產品
靶點詳情
-
功能:Receptor for Wnt proteins. Activated by WNT3A, WNT3, WNT1 and to a lesser extent WNT2, but apparently not by WNT4, WNT5A, WNT5B, WNT6, WNT7A or WNT7B. Contradictory results showing activation by WNT7B have been described for mouse. Functions in the canonical Wnt/beta-catenin signaling pathway. The canonical Wnt/beta-catenin signaling pathway leads to the activation of disheveled proteins, inhibition of GSK-3 kinase, nuclear accumulation of beta-catenin and activation of Wnt target genes. A second signaling pathway involving PKC and calcium fluxes has been seen for some family members, but it is not yet clear if it represents a distinct pathway or if it can be integrated in the canonical pathway, as PKC seems to be required for Wnt-mediated inactivation of GSK-3 kinase. Both pathways seem to involve interactions with G-proteins. May be involved in transduction and intercellular transmission of polarity information during tissue morphogenesis and/or in differentiated tissues (Probable).; (Microbial infection) Acts as a receptor for C.difficile toxin TcdB in the colonic epithelium.
-
基因功能參考文獻:
- FZD1 and CAIX might be important biological markers for the carcinogenesis, metastasis, invasion, and prognosis of pancreatic ductal adenocarcinoma PMID: 28921449
- aken together, our results suggest that Sp1 plays a role in human osteoblast differentiation and mineralization, which is at least partially mediated by Sp1-dependent transactivation of FZD1. PMID: 27695039
- The amplification of miR-135b suppressed non-small cell lung cancer chemoresistance by directly mediating FZD1 down-regulation. PMID: 27643554
- FZD1 expression was down-regulated by AP2 expression and mediated osteoblast differentiation and mineralization. PMID: 25369469
- our data demonstrate that FZD1 regulates PKCdelta, and the PKCdelta/AP-1 signalling transduction pathway plays an important role in drug resistance in MES-SA/Dx5 cells. PMID: 24814288
- Polymorphisms in several genes involved in the Wnt signaling pathway were associated with hepatic fibrosis or inflammation risk in HCV-infected males. PMID: 24386373
- ACE2 and FZD1 are prognosis markers in squamous cell/adenosquamous carcinoma and adenocarcinoma of gallbladder. PMID: 23921915
- Experiments demonstrate a role of E2F1 in osteoblast differentiation and mineralization and suggest that FZD1 is required, in part, for E2F1 regulation of osteoblast mineralization. PMID: 23806799
- Fz1 is a Wnt responsive gene in colon-derived tissues. Fz1 expression exhibited increased expression in normal mucosa only in close proximity to colon cancer PMID: 23442549
- FZD1 appears to mediate multidrug resistance by regulating the Wnt/beta-catenin pathway PMID: 22484497
- Soluble FZC18 and Wnt3a physically interact in a cell-free system and soluble FZC18 binds the frizzled 1 and 8 receptors. PMID: 22303445
- These results suggest that FZD1 expression is regulated in a haplotype-dependent manner in osteoblasts and that these same haplotypes may be associated with biomechanical indices of bone strength. PMID: 20051274
- Fz1 and LRP1 bind, which disrupts the receptor/coreceptor complex formation and leads to the repression of the canonical Wnt signaling PMID: 14739301
- subcellular Fz localization, through the association with other membrane proteins, is a critical aspect in regulating the signaling specificity within the Wnt/Fz signaling pathways PMID: 15252441
- Bone morphogenetic protein-2 modulates Wnt and frizzled expression and enhances the canonical pathway of Wnt signaling in normal keratinocytes PMID: 16442268
- Data demonstrate that Frizzled receptors can functionally replace mating factor receptors in yeast and offer an experimental system to study modulators of Frizzled receptors. PMID: 17895994
- a frizzled module in cell surface collagen 18 inhibits Wnt/beta-catenin signaling PMID: 18382662
- a cis-regulatory polymorphism in the FZD1 promoter region may have a functional role in determining bone structural geometry PMID: 18715140
- The proportion of frizzled-1 positive ovaries was lower in normal patients than in those with ovarian cancer or bening neoplasia PMID: 19148501
- FZD1 links epithelial/mesenchymal disruption to idiopathic pulmonary fibrosis. PMID: 17496152
顯示更多
收起更多
-
亞細胞定位:Cell membrane; Multi-pass membrane protein.
-
蛋白家族:G-protein coupled receptor Fz/Smo family
-
組織特異性:Expressed in adult heart, placenta, lung, kidney, pancreas, prostate, and ovary and in fetal lung and kidney.
-
數據庫鏈接:
Most popular with customers
-
-
YWHAB Recombinant Monoclonal Antibody
Applications: ELISA, WB, IHC, IF, FC
Species Reactivity: Human, Mouse, Rat
-
Phospho-YAP1 (S127) Recombinant Monoclonal Antibody
Applications: ELISA, WB, IHC
Species Reactivity: Human
-
-
-
-
-